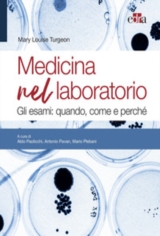

MEDICINA NEL LABORATORIO
Angeloni A.; Plebani M.; Pavan A.
Isbn : 9788821452970
Anno edizione : 2020
Argomento : Medicina E Infermieristica
Prezzo : € 59,00
Articolo acquistabile con 18App e Carta del Docente
Inviare una email di richiesta a professionale@libreriaromagnosi.com
Inviare una email di richiesta a professionale@libreriaromagnosi.com
Altri titoli dello stesso autore
Nessuno